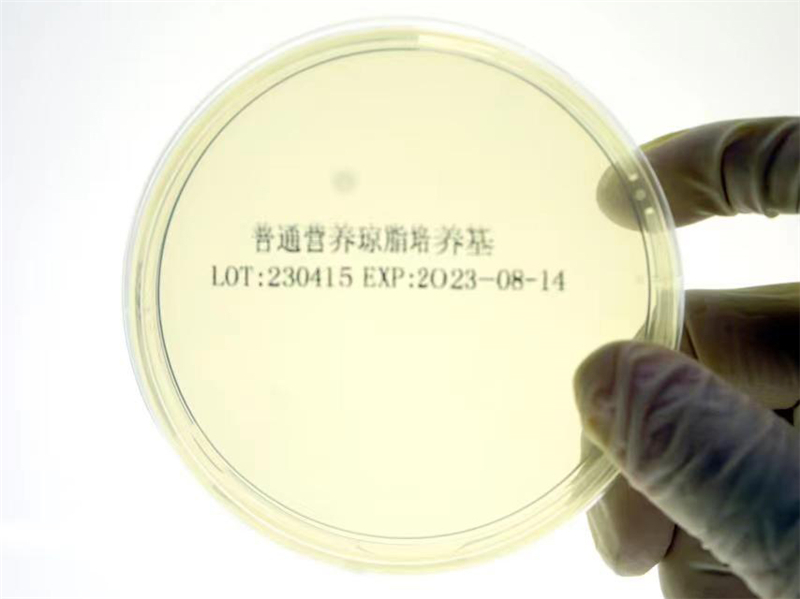
营养琼脂培养基说明书

营养琼脂培养基说明书
【产品名称】
通用名称:营养琼脂培养基
【包装规格】
普通营养琼脂培养基 | φ5.5cm×5、φ5.5cm×10、φ5.5cm×20、φ7cm×5、φ7cm×10、φ7cm×20、φ9cm×5、φ9cm×10、φ9cm×20、5ml、9ml、10ml |
胰蛋白胨大豆琼脂培养基(TSA) | φ7cm×5、φ7cm×10、φ7cm×20、φ9cm×5、φ9cm×10、φ9cm×20 |
R2A琼脂培养基(R2A) | φ7cm×5、φ7cm×10、φ7cm×20、φ9cm×5、φ9cm×10、φ9cm×20 |
胰化蛋白胨葡萄糖培养基(TGEA) | φ7cm×5、φ7cm×10、φ7cm×20、φ9cm×5、φ9cm×10、φ9cm×20 |
【预期用途】
用于细菌的分离培养,不具有微生物鉴别和药敏鉴别的作用。
【检验原理】
本培养基含微生物生长繁殖良好的营养物质,可促进细菌微生物的生长和繁殖。
【主要组成成分】
普通营养琼脂培养基(NA):
蛋白胨、氯化钠、牛肉浸出粉、琼脂、纯化水
胰蛋白胨大豆琼脂培养基(TSA):
胰酪胨、大豆木瓜蛋白酶水解物、氯化钠、琼脂、纯化水
R2A琼脂培养基(R2A):
酵母浸出粉、蛋白胨、酪蛋白水解物、葡萄糖、可溶性淀粉、磷酸氢二钾、无水硫酸镁、丙酮酸钠、琼脂、纯化水
胰化蛋白胨葡萄糖培养基(TGEA):
葡萄糖、胰化蛋白胨、牛肉抽出物、琼脂、纯化水
【储存条件及有效期】
2℃~30℃保存,切勿冻藏;在储存条件下,有效期6个月。
【适用仪器】
与恒温培养箱配合使用。
【样本要求】
1.培养时正确采集标本非常重要,正确的标本采集方法,合理的无菌环境操作是减少污染的基本要求。
2.使用时,将标本或菌种接种于培养基表面,置35℃~37℃培养箱孵育24小时以上,标本中的细菌或菌种能在培养基表面形成典型菌落,从而分纯菌株,培养分离出的菌株(菌落)可供进一步的鉴定和药敏试验等使用(整个操作过程中,应该遵循无菌操作技术和常规生物安全程序处理菌群的注意事项)。
【检验方法】
复温:取出培养基复温至室温,并作好标识。
接种:将取好的标本或菌株,采用划线或其他方法接种于培养基。
培养:将接种好的培养基置于35~37℃培养箱中培养24~48小时,观察结果。
【检验结果的解释】
细菌培养生长后,出现典型菌落。
【检验方法的局限性】
本产品仅适用于能在血平板上生长的细菌分离、培养和保存菌种。
【产品性能指标】
培养基接种质控菌株,生长情况应符合下表要求:
质控菌株 | 观察结果 |
金黄色葡萄球菌 | 生长良好,S型菌落,产生金黄色色素 |
大肠埃希氏菌 | 生长良好,半透明S型菌落 |
【注意事项】
1.本品仅用于体外微生物试验一次性使用。
2.全部样品、微生物培养物和接种产品都应视为具有感染性,应由受过训练的专业技术人员操作,整个操作过程中,应该遵循无菌操作技术和按生物安全操作规范处理。
3.使用前应仔细阅读说明书,在有效期内使用。
4.如培养基出现变色、污染菌生长、包装破损、变形或包装袋开启等情况,请勿使用。
5.开封后未使用完的培养基要及时放到冰箱冷藏储存,避免干裂。
6.在冰箱储存较久的培养基容易出现较多的冷凝水,请在洁净环境下将水倾出,然后在培养箱放置一段时间,待其表面干燥之后再接种。
【标识的解释】
LOT:生产批号; EXP:有效期; NA:普通营养琼脂培养基缩写; TSA:胰蛋白胨大豆琼脂培养基缩写; R2A:R2A琼脂培养基缩写; TGEA:胰化蛋白胨葡萄糖培养基缩写
【参考文献】
《全国临床检验操作规程》第三版、YY/T 0577-2005《营养琼脂培养基》标准。
【运输条件】可常温运输
【基本信息】
生产企业名称:四川好培养生物工程有限公司
住 所:成都市蒲江县寿安镇博世路555号19栋
联系方式: +0086-028-88554415
售后服务单位:四川好培养生物工程有限公司
联系方式: +0086-028-88554415
生产地址:成都市蒲江县寿安镇博世路555号19栋、成都市蒲江县寿安街道新园三路1088号
生产许可证编号:川蓉食药监械生产备20170004号
网 址:www.hapyear.com
【医疗器械注册证书编号/产品技术要求编号】
川蓉械备20160100号
【说明书批准及修改日期】
2025年08月08日